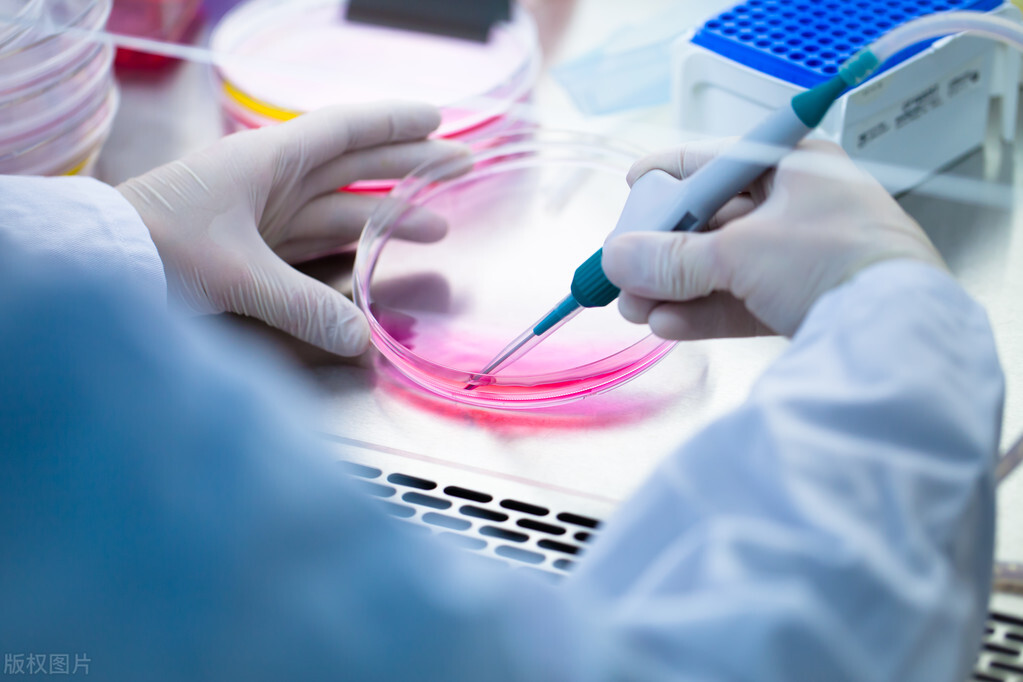
糖尿病干细胞移植能治好费用多少,一型糖尿病干细胞移植可以治愈不

摘要:近年来,干细胞应用糖尿病治疗已被广泛研究中。
最近看到一个知友话题#29岁得了糖尿病还能结婚吗?# 下面一堆网友展开讨论并非常震惊,现在糖尿病发病群已经这么年轻了吗?其实这主要跟现代经济、物质水平、饮食、生活习惯以及年轻人的喜好相关的。
糖尿病是一种可防可控,但是非常难以治愈的慢性疾病,一旦患上糖尿病其治疗就是一个漫长的过程,且绝大多数难以治愈,只能通过相应的治疗手段和强制改变生活方式进行干预,来控制血糖和预防并发症。

数据显示:截至2021年,全球约有5.37亿的患者。中国糖尿病患者人数达1.41亿人,发病率高达12.8%,相当于每10个人里就有1个糖尿病患者。
其中,90%以上是2型糖尿病。20—79岁糖尿病患者总数、因糖尿病导致的死亡人数均排名全球第一,20—79岁群体因糖尿病产生的医疗费用排名全球第二。据估计,2045年我国20—79岁糖尿病患者数将上升到1.744亿人。
有人说糖尿病就像是近视眼,一旦发生就会伴随患者一辈子,而且“度数”越来越深,随着糖尿病的进展,药量也会不断加大,需要长期使用胰岛素,只能缓解,无法治愈。
糖尿病能彻底治愈吗?
根据现有的医学技术和手段,糖尿病还是无法彻底治愈的慢性疾病。不过,如果是早期糖尿病患者,自身胰岛素功能较好,还是可以通过调节饮食、运动、控制体重来达到长期控糖的目的,且不用长期药物治疗;也有个别的新发糖尿病患者,在药物治疗一段时间后,其自身胰岛素功能也会有一定的恢复,停药后也可长期保持正常的血糖水平。
但上述情况确实少见,一般会随着年龄的增长,糖尿病的发病率逐渐增加,其病情也会逐渐向严重进展。

目前比较常规的糖尿病治疗方法主要包括控制饮食、增加活动量、口服降糖药、注射胰岛素等。但这些治疗方法效果有限,且不能阻断并发症、阻止病程进展。
为了突破治疗瓶颈,糖尿病领域的相关研究者一直在不断努力。近年来,已经出现了一些新的治疗方向给糖尿病患者带来了福音。
干细胞移植是如何治疗糖尿病的?
基于糖尿病其病因的复杂性,简单来说就是人体内的胰岛细胞*工罢**、怠工,造成体内正常分泌的胰岛素减少或胰岛素功能的减弱,从而不能有效的降低血糖,引起糖尿病的发生。
针对此根本病因,采用干细胞移植重建胰岛细胞功能的方式治疗糖尿病,使消极怠工的胰岛细胞恢复功能,是迄今人们认为的最理想的糖尿病治疗模式。

干细胞是一类具有多种分化潜能的细胞,在适当的环境下能向各种细胞分化,可像“种子”一样在各种组织器官中生长,并可将一定数量的自体干细胞通过动脉导管迁移到胰腺组织中,“种子”就会在胰腺组织微环境的诱导下分化增殖为胰岛样细胞,替代损伤的胰岛β细胞分泌胰岛素,起到治疗糖尿病的作用。
关于干细胞治疗糖尿病,目前主要三种方法:自体骨髓干细胞移植、自体血液干细胞移植和脐血干细胞移植:

1、自体骨髓干细胞移植:首先在无菌条件下采集患者的骨髓,然后分离、纯化,提取骨髓中的干细胞,再注入患者体内。
2、自体血液干细胞移植:先用粒细胞集落刺激因子治疗4-5天,其目的是把患者骨髓中的干细胞“趋赶”到外周血中,当骨髓干细胞在外周血中达到一定数量后,就用血细胞分离机分离出这些干细胞,再注入患者体内。
3、脐血干细胞移植:与前面两种方法不同,脐血干细胞不是患者自身的,是外源性的,所以患者不需要采集骨髓或用药物刺激。

自体造血干细胞在使用了大剂量免疫*制剂抑**和自体采集的干细胞回输后,拟通过造血和免疫系统的重建和干细胞对胰岛细胞促进再生作用,来达到长期缓解糖尿病的临床治疗目的。
糖尿病本身属于内分泌科疾病,其免疫系统有一定的缺陷,因此,在使用干细胞移植来达到重建和修复目的,会起到一定的效果。另外,糖尿病患者体内糖分不断在升高,会伴随影响患者的饮食生活,干细胞移植治疗是一种新型的手术方式,不仅能够起到控制病情的效果,还能有效帮助患者进行身体的修复。
干细胞治疗适合哪类糖尿病,能彻底治好吗?
截止目前的研究表明,干细胞移植治疗的范围主要涉及Ⅰ型糖尿病和Ⅱ型糖尿病。另外,有些糖尿病引起的并发症,如糖尿病心肌损害、糖尿病足、糖尿病视网膜病变、糖尿病肾病等并发症,同样在临床研究中表现出了积极的效果。
干细胞移植可以促进胰岛β细胞的再生,保护内源性胰岛β细胞免遭凋亡,并改善外周组织的胰岛素抵抗,降低血糖和糖尿病副反应的风险。

2022年5月解放军总医院在《Stem Cells Research&Therapy》上发表了脐带源间充质干细胞在中国成人2型糖尿病中的II期试验,结果显示脐带间充质干细胞移植有效降低了2型糖尿病患者的胰岛素抵抗。
干细胞治疗还不能彻底根除糖尿病!
干细胞移植治疗糖尿病,还处于临床试验阶段,效果还不明确,所以并不能明确干细胞移植能否彻底治疗糖尿病。
干细胞来源较为广泛,如脐带、骨髓,而且干细胞具有自我增殖、分化、修复功能,有可能分化成为胰岛β细胞,分泌胰岛素,治疗糖尿病。另外,干细胞具有修复破损组织的功能,胰腺出现损伤后,干细胞可以发挥再生、修复作用,以达到治疗糖尿病的目的。
写在最后:
随着医疗技术的快速发展,相信干细胞移植疗法也将会越来越成熟,必将会为糖尿病的治疗打开一种新的治疗方向,并造福广大糖尿病患者!